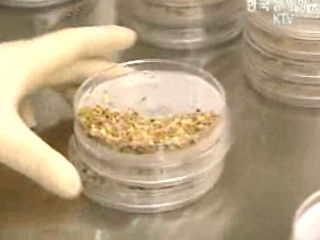
농산물 10종, 중금속 허용기준 신설

-
 용산기지 민족 공원 탈바꿈, 복합시설 개발
용산 미군기지터의 공원 조성을 위한 특별법이 26일 국무회의를 통과했습니다. 용산 기지 전체를 공원으로 개발하되 기지 이전 재원 마련을 위해 일부를 복합시설용도로 개발합니다.
강동원 기자>
정부는 청와대에서 노무현 대통령 주재로 국무회의를 열고 용산 민족 역사공원 조성과 주변 지역 정비에 관한 특별법 제정안을 의결했습니다.
미군기지 터 전체를 공원화하...
방송일자 : 2006.12.26
용산기지 민족 공원 탈바꿈, 복합시설 개발
용산 미군기지터의 공원 조성을 위한 특별법이 26일 국무회의를 통과했습니다. 용산 기지 전체를 공원으로 개발하되 기지 이전 재원 마련을 위해 일부를 복합시설용도로 개발합니다.
강동원 기자>
정부는 청와대에서 노무현 대통령 주재로 국무회의를 열고 용산 민족 역사공원 조성과 주변 지역 정비에 관한 특별법 제정안을 의결했습니다.
미군기지 터 전체를 공원화하...
방송일자 : 2006.12.26
-
 국사·세계사 통합, 역사·과목 독립
우리국민의 대다수가 역사 교육을 강화해야 한다는 데 공감하고 있다는 보도 전해 드린적이 있습니다.
교육부가 이에따라 역사를 일반 사회과목에서 분리시키고 ‘동아시아사’를 신설하는 등의 역사교육 강화 방안을 내놨습니다.
강명연 기자>
오는 2010년 중학교 1학년부터 국사와 세계사가 역사로 통합되고 고등학교 선택과목으로 동아시아사가 신설됩니다.
교육...
방송일자 : 2006.12.26
국사·세계사 통합, 역사·과목 독립
우리국민의 대다수가 역사 교육을 강화해야 한다는 데 공감하고 있다는 보도 전해 드린적이 있습니다.
교육부가 이에따라 역사를 일반 사회과목에서 분리시키고 ‘동아시아사’를 신설하는 등의 역사교육 강화 방안을 내놨습니다.
강명연 기자>
오는 2010년 중학교 1학년부터 국사와 세계사가 역사로 통합되고 고등학교 선택과목으로 동아시아사가 신설됩니다.
교육...
방송일자 : 2006.12.26
-
 내년부터 운전기사 폭행하면 엄벌
내년 2월부터 버스나 택시 운전기사를 때리면 3년 이상의 징역 또는 2천만원 이하의 벌금형을 받게 됩니다.
건설교통부에 따르면 운행중인 자동차 운전자에 대한 폭행에 대해 가중 처벌하는 내용을 골자로 한 `특정범죄가중처벌법 개정안`이 최근 정기국회에서 통과돼 유예기간을 거쳐 내년 2월부터 시행에 들어갑니다.
이번 개정안은 운행중인 대중교통 운전자를 상...
방송일자 : 2006.12.26
내년부터 운전기사 폭행하면 엄벌
내년 2월부터 버스나 택시 운전기사를 때리면 3년 이상의 징역 또는 2천만원 이하의 벌금형을 받게 됩니다.
건설교통부에 따르면 운행중인 자동차 운전자에 대한 폭행에 대해 가중 처벌하는 내용을 골자로 한 `특정범죄가중처벌법 개정안`이 최근 정기국회에서 통과돼 유예기간을 거쳐 내년 2월부터 시행에 들어갑니다.
이번 개정안은 운행중인 대중교통 운전자를 상...
방송일자 : 2006.12.26
-
 주식 외상거래 사실상 금지
내년 5월부터 주식의 투기성 단타 매매를 부추기는 외상거래, 즉 미수거래가 사실상 금지됩니다.
금융감독원은 이같은 내용의 주식 미수거래와 신용거래의 개선 방안을 밝혔습니다.
방안에 따르면 결제일에 매수잔금을 다 내지 않은 투자자는 이후 30일간은 주식을 매수할 때 증거금으로 현금 100%를 증권사에 내야 하는 `동결계좌`제가 도입됩니다.
또 내년 2...
방송일자 : 2006.12.26
주식 외상거래 사실상 금지
내년 5월부터 주식의 투기성 단타 매매를 부추기는 외상거래, 즉 미수거래가 사실상 금지됩니다.
금융감독원은 이같은 내용의 주식 미수거래와 신용거래의 개선 방안을 밝혔습니다.
방안에 따르면 결제일에 매수잔금을 다 내지 않은 투자자는 이후 30일간은 주식을 매수할 때 증거금으로 현금 100%를 증권사에 내야 하는 `동결계좌`제가 도입됩니다.
또 내년 2...
방송일자 : 2006.12.26
-
 소외계층 지원 에너지재단 공식 출범
소외계층에 대한 고효율 보일러 보급 등 에너지 복지지원을 맡을 에너지재단이 26일 서울 여의도 한국전력 남서울 전력관리처에서 정식 출범했습니다.
에너지 기본법에 담겨 있는 국가와 에너지 공기업의 저소득층 지원의무를 담당하기 위해 설립된 에너지재단은 정유업체와 한국전력, 한국석유공사와 한국가스공사 등 에너지 관련 공기업들이 참여해 설립됐습니다.
정세균...
방송일자 : 2006.12.26
소외계층 지원 에너지재단 공식 출범
소외계층에 대한 고효율 보일러 보급 등 에너지 복지지원을 맡을 에너지재단이 26일 서울 여의도 한국전력 남서울 전력관리처에서 정식 출범했습니다.
에너지 기본법에 담겨 있는 국가와 에너지 공기업의 저소득층 지원의무를 담당하기 위해 설립된 에너지재단은 정유업체와 한국전력, 한국석유공사와 한국가스공사 등 에너지 관련 공기업들이 참여해 설립됐습니다.
정세균...
방송일자 : 2006.12.26
-
 세계적 투자은행들 `내년엔 한국이 유망`
세계적인 투자은행들이 내년에는 아시아증시 가운데 한국증시가 유망하다는 분석을 잇따라 내놓고 있습니다.
일부 투자은행은 내년 한국증시를 최고 유망 시장으로 꼽는 데 주저하지 않고 있으며, 중국과 인도와 달리 전체적으로 긍정적인 평가를 내리고 있습니다.
씨티그룹이 한국증시를 아시아증시 최고 유망시장으로 지목한 데 이어 맥쿼리도 외국인의 한국증시로의 복귀...
방송일자 : 2006.12.26
세계적 투자은행들 `내년엔 한국이 유망`
세계적인 투자은행들이 내년에는 아시아증시 가운데 한국증시가 유망하다는 분석을 잇따라 내놓고 있습니다.
일부 투자은행은 내년 한국증시를 최고 유망 시장으로 꼽는 데 주저하지 않고 있으며, 중국과 인도와 달리 전체적으로 긍정적인 평가를 내리고 있습니다.
씨티그룹이 한국증시를 아시아증시 최고 유망시장으로 지목한 데 이어 맥쿼리도 외국인의 한국증시로의 복귀...
방송일자 : 2006.12.26
-
 한국 최초 우주인 최종후보 2명 확정
한국 최초의 우주인 후보자 두 명이 최종 선발됐습니다. 만8천 대 1의 치열한 경쟁을 통과한 두 사람 가운데 한 명이 건국 이래 처음으로 우주로 날아가 임무를 수행하게 됩니다.
김현아 기자>
한국 최초의 우주인 후보가 탄생했습니다.
고산 씨와 이소연 씨가 바로 영광의 주인공.
남자 후보인 고산씨는 서른 살로 삼성종합기술원에서 인공지능을 연구하는 연...
방송일자 : 2006.12.26
한국 최초 우주인 최종후보 2명 확정
한국 최초의 우주인 후보자 두 명이 최종 선발됐습니다. 만8천 대 1의 치열한 경쟁을 통과한 두 사람 가운데 한 명이 건국 이래 처음으로 우주로 날아가 임무를 수행하게 됩니다.
김현아 기자>
한국 최초의 우주인 후보가 탄생했습니다.
고산 씨와 이소연 씨가 바로 영광의 주인공.
남자 후보인 고산씨는 서른 살로 삼성종합기술원에서 인공지능을 연구하는 연...
방송일자 : 2006.12.26
-
 위장전입 아파트 당첨자 81명 검거
인천경찰청은 위장전입을 통해 아파트를 부정하게 당첨받거나 분양권을 전매한 혐의로 81명을 불구속 입건했다고 밝혔습니다.
경찰에 따르면 이들은 지난 10월 인천 소래와 논현지구에서 분양된 33~65평형 아파트 분양공고 직전 인천으로 위장전입해 인천 거주자 우선 분양 자격을 얻은 뒤 아파트 청약에 당첨된 혐의를 받고 있습니다.
이들은 분양공고문에 인천 ...
방송일자 : 2006.12.26
위장전입 아파트 당첨자 81명 검거
인천경찰청은 위장전입을 통해 아파트를 부정하게 당첨받거나 분양권을 전매한 혐의로 81명을 불구속 입건했다고 밝혔습니다.
경찰에 따르면 이들은 지난 10월 인천 소래와 논현지구에서 분양된 33~65평형 아파트 분양공고 직전 인천으로 위장전입해 인천 거주자 우선 분양 자격을 얻은 뒤 아파트 청약에 당첨된 혐의를 받고 있습니다.
이들은 분양공고문에 인천 ...
방송일자 : 2006.12.26
-
 농산물 10종, 중금속 허용기준 신설
식품의약품안전청은 쌀과 옥수수 등 국민이 많이 소비하는 농산물 10종에 대한 중금속 허용 기준을 신설했다고 밝혔습니다.
이로써 중금속에 오염된 농산물의 생산과 수입, 유통을 막을 수 있는 법적 근거가 마련됐습니다.
이 기준에 따르면 농산물의 중금속 잔류허용기준은 납의 경우 kg당 mg으로 쌀과 옥수수,대두, 팥이 0.2 이하, 고구마와 감자, 파, ...
방송일자 : 2006.12.26
농산물 10종, 중금속 허용기준 신설
식품의약품안전청은 쌀과 옥수수 등 국민이 많이 소비하는 농산물 10종에 대한 중금속 허용 기준을 신설했다고 밝혔습니다.
이로써 중금속에 오염된 농산물의 생산과 수입, 유통을 막을 수 있는 법적 근거가 마련됐습니다.
이 기준에 따르면 농산물의 중금속 잔류허용기준은 납의 경우 kg당 mg으로 쌀과 옥수수,대두, 팥이 0.2 이하, 고구마와 감자, 파, ...
방송일자 : 2006.12.26
-
 총액인건비 제도 전면 확대
정부는 각 기관에 조직과 보수, 예산 운영의 자율성을 부여해 성과중심의 조직운영체제를 확립하기 위해 내년부터 전 중앙행정기관에 총액인건비제도를 전면 시행하기로 했습니다.
지난해 7월 처음 도입한 총액인건비제도는 현재 8개 부처 44개 책임운영기관에서 시범실시 중에 있으며 내년도부터 전 중앙행정기관으로 확대될 계획입니다.
총액인건비제도란 각 부처별로 ...
방송일자 : 2006.12.26
총액인건비 제도 전면 확대
정부는 각 기관에 조직과 보수, 예산 운영의 자율성을 부여해 성과중심의 조직운영체제를 확립하기 위해 내년부터 전 중앙행정기관에 총액인건비제도를 전면 시행하기로 했습니다.
지난해 7월 처음 도입한 총액인건비제도는 현재 8개 부처 44개 책임운영기관에서 시범실시 중에 있으며 내년도부터 전 중앙행정기관으로 확대될 계획입니다.
총액인건비제도란 각 부처별로 ...
방송일자 : 2006.12.26